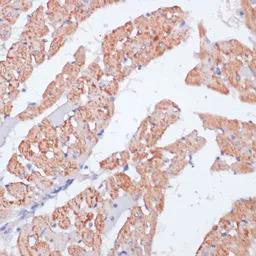
beta Arrestin 1 antibody

相关产品推荐更多 >
万千商家帮你免费找货
0 人在求购买到急需产品
- 详细信息
- 文献和实验
- 技术资料
- 免疫原:
Recombinant fusion protein containing a sequence corresponding to amino acids 169-418 of human ARRB1 (NP_004032.2).
- 亚型:
IgG
- 形态:
Liquid
- 保存条件:
Store as concentrated solution. Centrifuge briefly prior to opening vial. For short-term storage (1-2 weeks), store at 4ºC. For long-term storage, aliquot and store at -20ºC or below. Avoid multiple freeze-thaw cycles.
- 克隆性:
Polyclonal
- 标记物:
Unconjugated
- 适应物种:
Human, Mouse, Rat
- 保质期:
12 months from the shipping date of the product.
- 抗原来源:
Human
- 目录编号:
GTX30065
- 级别:
Primary Antibodies
- 库存:
Available
- 供应商:
GeneTex
- 宿主:
Rabbit
- 应用范围:
WB, ICC/IF, IHC-P, IP
- 浓度:
Batch dependent (Please refer to the vial label for the specific concentration.)
- 靶点:
beta Arrestin 1
- 抗体英文名:
beta Arrestin 1 antibody
- 抗体名:
beta Arrestin 1 抗体
- 规格:
100 μl

WB analysis of various sample lysates using GTX30065 beta Arrestin 1 antibody.
Dilution : 1:1000
Loading : 25μg per lane

IHC-P analysis of mouse spleen tissue using GTX30065 beta Arrestin 1 antibody.
Dilution : 1:100
IHC-P analysis of rat heart tissue using GTX30065 beta Arrestin 1 antibody.
Dilution : 1:100

IP analysis of K-562 cell lysate using GTX30065 beta Arrestin 1 antibody.
Antibody amount : 3μg / 200μg lysate
Dilution : 1:1000

ICC/IF analysis of HeLa cells using GTX30065 beta Arrestin 1 antibody.
Blue : DAPI
风险提示:丁香通仅作为第三方平台,为商家信息发布提供平台空间。用户咨询产品时请注意保护个人信息及财产安全,合理判断,谨慎选购商品,商家和用户对交易行为负责。对于医疗器械类产品,请先查证核实企业经营资质和医疗器械产品注册证情况。
 文献和实验
文献和实验Anticardiolipin Antibody and Anti-beta 2 Glycoprotein I Antibody Assays
) antibodies and anti-beta 2 glycoprotein I (β2-GPI) antibodies. Other autoantibodies, such as those directed against anionic phospholipids, can also be assayed; however they are not of clinical significance. Participation in a quality assurance
。 如果beta-catenin抗体不好使,或者EGFP太大影响定位的话,还可以构建Flag标签类载体,转染细胞,加入药物,用抗Flag抗体免疫荧光检测,荧光显微镜下观察就好了。 wangjh28 但按照事先的推测,处理了以后会下调该基因的表达 我觉得科学不能有事先的推测的结果,这样容易受思维定势的影响,而忽略了新发现 dongreyuan 我打算用SAB的β-catenin(Ab-37)Antibody,说明
in 200 mls Solution A. Repeat wash. Pellet cells as above and resuspend in 4 mls Solution A. Reserve 2 mls of the cell suspension. Spheroplast the remaining 2 ml of the cell suspension by addition of beta-mercaptoethanol to 0.1, glusulase
 技术资料
技术资料暂无技术资料 索取技术资料






![AKT (phospho Ser473) antibody [LP18]](https://img1.dxycdn.com/2022/0328/852/1565194183628700453-14.jpg!wh200)


![V5 tag antibody [SV5-Pk4]](https://img1.dxycdn.com/2022/0328/133/2469542925083400453-14.jpg!wh200)

